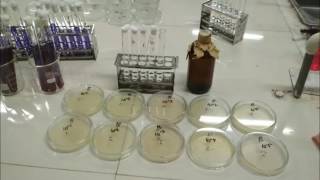

- Pengolahan Limbah Dengan Sistem Lumpur Aktif ( STIENAS )

video ini di buat untuk memenuhi tugas APLIKOM di STIENAS Tentang Pengolahan Limbah Dengan Metode Lumpur Aktif. Watch Now
Watch Now
- MENGENAL PENGOLAHAN AIR LIMBAH LUMPUR AKTIF: ACTIVATED SLUDGE

Activated Sludge: Pengolahan air Limbah Lumpur Aktif, Arasi, MLSS, Efektvitas, MLSS. Watch Now
Watch Now
- Pengolahan Limbah Cair Industri dengan Teknik Activated Sludge Process

Video ini dibuat dalam rangka untuk menyelesaikan tugas dari mata kuliah Teknik Lingkungan Jurusan Teknik Kimia Universitas Islam Indonesia. Video ini ... Watch Now
Watch Now
- PENGOLAHAN LIMBAH INDUSTRI dgn sistem LUMPUR AKTIF / BAKTERI murni

IPAL INDUSTRI MAKANAN & MINUMAN SISTEM BAKTERI MURNI. Watch Now
Watch Now
- ABDUL HARIS (F1C116079) Pengolahan Limbah Organik Industri Menggunakan Lumpur Aktif

Tugas Mikrobiologi Umum. Watch Now
Watch Now
- METODE LUMPUR AKTIF ACTIVATED SLUDGE

 Watch Now
Watch Now
- PENGOLAHAN LIMBAH CAIR

IPAL dengan sistem bakteri AEROB Tampa CHEMICAL dapat di aplikasikan di industri makan & minuman, rumah sakit, farmasi, tekstil, dll, dapat ... Watch Now
Watch Now
- Animasi 3D Ipal Komunal Lengkap

IPAL Komunal adalah Instalasi Pengolahan Air Limbah yang merupakan sarana untuk mengolah limbah yang berbentuk cair misalnya seperti limbah dari WC, ... Watch Now
Watch Now
- Poltekkes JKT II Penurunan Kadar COD, Jumlah Bakteri serta Penjernihan Pada Air Limbah Domestik Deng
Olimpiade Kesehatan Lingkungan Indonesia Poltekkes JKT II Penurunan Kadar COD, Jumlah Bakteri serta Penjernihan Pada Air Limbah Domestik ... Watch Now
Watch Now
- Elektrokoagulasi HIMATEK UNJANI

 Watch Now
Watch Now
- SVI untuk MENGECEK KUALITAS LUMPUR

SVI dipergunakan untuk mengck kualitas lumpur Sistem Pengolahan Lumpur Aktif Activated Sludge. Air tangki aerasi dimasukkan ke tabung gelas ukur volume ... Watch Now
Watch Now
- Teknologi Biofilter Anaerob - Aerob Untuk Pengolahan Air Limbah (1)

Iptek talk episode 31 Agustus 2010 mengangkat topik Teknologi Biofilter Aerob -- Anaerob untuk Pengolahan Air Limbah , dibahas oleh pakar yang ... Watch Now
Watch Now
- PENGOLAHAN LIMBAH DENGAN METODE ADSORPSI DAN FILTRASI - SMA PUSRI Palembang

ZEOLIT : MENYARING KEKERUHAN YANG DISEBABKAN OLEH PARTIKEL KECIL DAN LUMPUR, MENGHILANGKAN KANDUNGAN AMONIAK DALAM AIR, ... Watch Now
Watch Now
- vat leaching, mengolah emas sistem perendaman

Vat leaching, mengolah emas dengan menggunakan sianida dan karbon aktif sistem perendaman. Watch Now
Watch Now
- Pengolahan Tambang Emas

Video yang menjelaskan tentang proses pengolahan tambang emas. Watch Now
Watch Now
- Satuan Proses ACTIVATED SLUDGE

 Watch Now
Watch Now
Monday, September 23, 2019
Pengolahan Limbah Dengan Metode Lumpur Aktif
Subscribe to:
Post Comments (Atom)
No comments:
Post a Comment